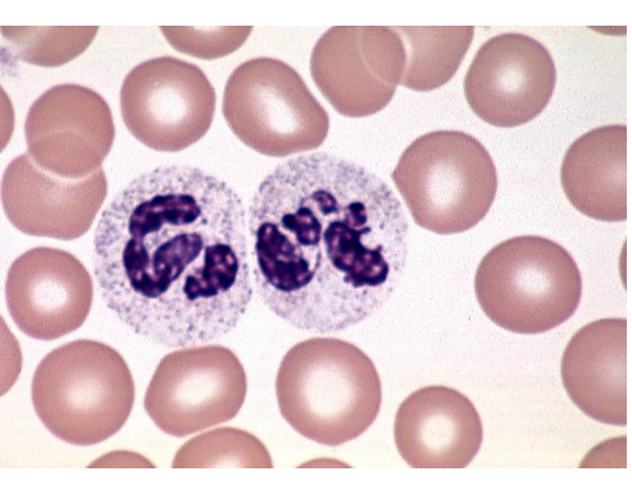
term image
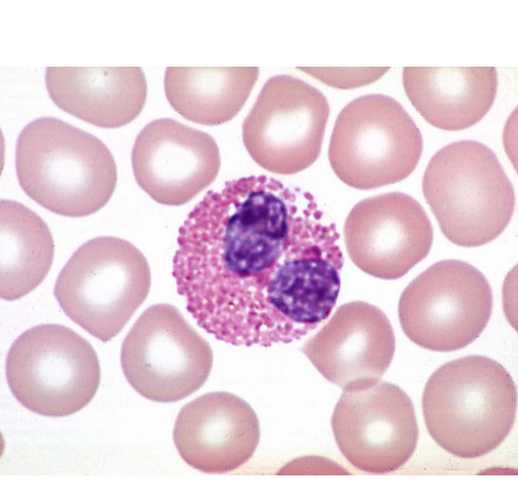
term image
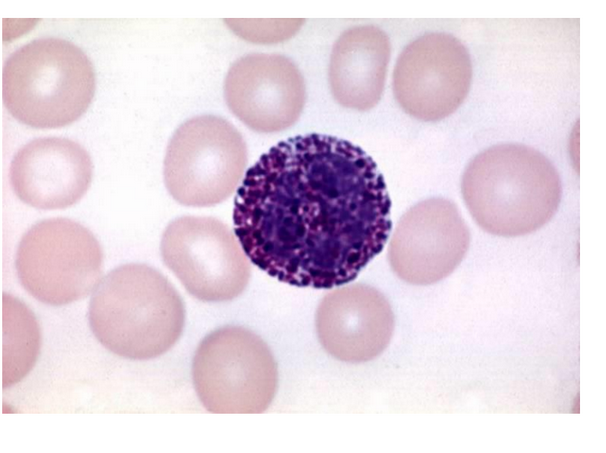
term image

1/88
Looks like no tags are added yet.
Name | Mastery | Learn | Test | Matching | Spaced | Call with Kai |
|---|
No study sessions yet.
pourqoui apparaise-t-il rouge?
riche en proteine

faisceau de cellules musculaire

perimysium = TC autour des faisceau musculaire

tissue muscuailre strie squelettique
comment reconnaitreun itssue musculaire strie squelettique
striations, noyaux peripheriques

bande A(gauche), bande I (milieu), strie Z(droite)

endomysiouem (TC entre les tissues musculaire strie squelettique)



I (myofilaments fins), A (myofilaments epais + fins), H(myofilaments epais) M(ponts M entre myofilements epais)













distuinguer entre myocradiaque et cardique strie squelettique
en cercle


tissue musculaire lisse




artere elastique


cellules myoepitheliales


ou dans le SNC (blanche ou grise)
substance grise


ou dans le SNC (blanche ou grise)

Quelle coloration met en contraste les neurotubules et les neurofilaaments
impregnation argentique











quelle coloration?
cajal coloration




qu’est-ce que c’est
ganglion

























HES
Periodic Acid Schiff

microvillosite

glycocalyx + biocuche phospholidiques

cadre obturant

epithelium pseudostratifie



difference entre kcouche cornee type A et type B
type A = couche cornee > couche granuleuse + couche epinaire
type B = couche cornee < couche granuleuse + couche epinaire

desmosome = 5 lines

jct GAP

desmosome

nodule de bizzozero

melanocytes

quelle coloration
FONTANA

glande de lieberkuhn

prophase

metaphase

anaphase

glande sudoripare eccrine



glande sudoripare faussemtn apocrine
exocrine, simple, tubulaire pelotonne, sueur, merocrinie

glande sudoripare eccrine
exocrine, simple, tubulaire pelotonne, sueur, eccrine

glande de lieberkuhn
exocrine, simple, tubulaire droite, mucus, merocrine

glande sebacee
exocrine, simple, alveolaire, lipidique, holocrine
glande parotide
exocrine, composee, acineuse, sereuse, merocrine, pure
glande sous-mandibilaire
exocrine, composee, tubulo-acineuse, sereuse+muqueuse,merocrine,mixte



CANAL COLLECTEUR → BISTRATIFIE

glande sub-linguale
exocrine, composee, sero-muqueuse, tubulo-acineuse, exocrine, mixte

croissant de gianuzzi

glande cortico-surrenaliennes
endocrine, cordonnale, hormones lipidiques, eccrines
glande thyroide
endocrine, folliculaire, hormones T3,T4, merocrine

mastocyte

collagene type 1

collagene type 3











coloration?
ORCEINE






coloration
Von Kossa

neutrophile → 4 noyeau
eosinophile 2 noyau rouge
basophile 2 noyau. purple thignsa round